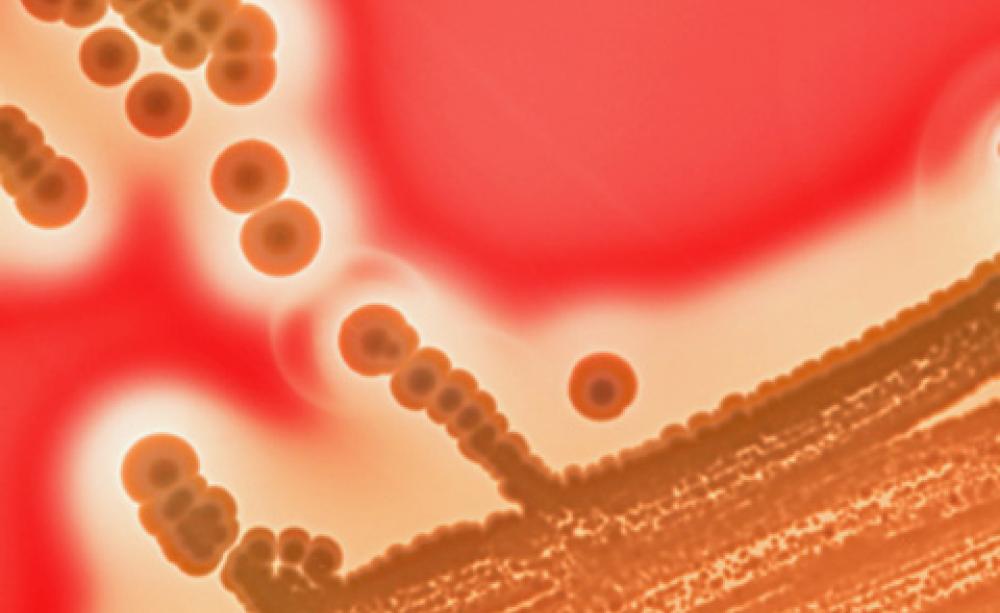
Bacteria

'We infer that the local animal population is unlikely to be the major source of resistance diversity for humans. This suggests that current policy emphasis on restricting antimicrobial use in domestic animals may be overly simplistic.'
It was a bold conclusion that potentially threw a spanner in the works of the medical experts and campaigners pushing for new restrictions on the high-levels of farm antibiotic use in Europe.
Researchers, led by the University of Glasgow, looked at data on antimicrobial resistance in salmonella cases in farm animals and humans in Scotland and concluded that significant differences between the two made it 'unlikely' that local farm animals were the major source of resistance in humans.
'There were significantly more human-only types of resistance than we might have expected if the animal and human microbial communities were well-mixed,' said study co-author Professor Daniel Haydon, 'suggesting that the risk of resistances passing from animals to humans is lower than previous research has indicated.'
The authors went on to question moves to restrict the use of antimicrobials in farming - a direct challenge to EU policymakers who see growing evidence of its role in the emergence of new untreatable superbugs, albeit still a much smaller role than that arising from misuse and overuse in humans.
However, following accusations of bias by a leading academic and expert advisor to the WHO, the study's conclusions, published in the prestigious journal Proceedings of the Royal Society, are looking increasingly flawed.
EU moves to restrict antibiotics
Everyone agrees on the need to reduce the unnecessary use of antibiotics. If we don't find ways to cut our use in animals and humans then pretty soon serious infections, resistant to our existing and slowly emerging new antibiotics, are going to become untreatable.
But from this unified position, views about what to do to reduce antibiotic use diverge.
Representatives of the World Health Organisation (WHO), the EU parliament and campaign groups like the Soil Association all call for a crackdown on antibiotic use in farming, which uses an estimated 50 per cent of all antibiotics prescribed in Europe. While accepting that human misuse is the biggest factor in the emergence and spread of antimicrobial resistance like MRSA, they say gross misuse in intensive farming is adding to the problem and is easier to tackle.
Farming lobby and veterinary groups dispute the urgent need to reduce antibiotic use. While supporting the need for 'prudent use' of antibiotics they say it must not come at the expense of animal health and welfare. Essentially arguing in favour of the status quo.
In political terms that position has been coming under increasing attack, culminating in a vote in the EU parliament in October 2011 that called for a ban on the prophylactic use of antibiotics (given as a preventative measure before animals get sick). MEPs also called for an end to the use of those antibiotics that are critically important in human health.
The use of antibiotics is only morally justified if it was to 'cure a problem', German MEP Dagmar Roth-Behrendt, who has been pushing for new restrictions, told the Ecologist. She said the farming industry is 'damaging the reputation of farmers' and putting 'public trust confidence at risk' by its failure to restrict the use of antibiotics.
A 'flawed' study?
The pro-farming antibiotics lobby was quick to jump on the conclusions of the new study, with the British Veterinary Association (BVA) putting out a press notice headed: 'New research suggests animals not to blame for human antimicrobial resistance'. Adding that it, 'calls into question policies that restrict the veterinary use of antimicrobials in order to reduce resistance in humans, such as recent moves in the European Parliament to ban the prophylactic use of antimicrobials in livestock'.
Press coverage followed a similar argument.
The study provided the perfect opportunity for BVA president Carl Padgett to bolster his argument against new regulations. He has previously expressed concern that decisions on the antibiotic resistance crisis were 'being dictated by politicians and technocrats in Brussels looking for easy answers with little or no regard to the scientific evidence'.
However, not everyone was as quick to accept such conclusions.
A leading expert on infectious diseases, Professor Peter Collignon, told the Ecologist that the conclusions were a 'gross misrepresentation of the data'. Far from showing large differences, he says, their results showed that the antibiotic resistance seen in the vast majority of farm animals was exactly the same as what is seen in humans.
In an outspoken attack, Professor Collignon, an advisor to the World Health Organization (WHO), says, 'I find this paper and the press release by the BVA to be not based on the data presented, deceptive and I think purposely misleading. This needs to be apologised for and corrected by the authors.'
The study may have only looked at one example, resistance found in salmonella cases in Scotland, but it made bold conclusions suggesting a re-think on EU moves against restricting antibiotic use in farm animals.
Researchers concluded that because a large number of the different antibiotic resistance types were only found in humans and not animals, farm animals in Scotland were unlikely to be a major source for the resistant strains causing such widespread concern amongst the medical profession.
However, most of the human-only resistant types found in the study were found in single numbers, making up a total of just 5 per cent of the resistance. Whereas, the rest, 95 per cent of the resistant types, were found in humans and animals.
'I don't believe that anyone who sees the raw data can come to any conclusion other than that the vast majority of salmonella types in people and food animals seem to have very similar antibiotic resistance profiles,' says Professor Collignon.
He also believes the study is flawed by relying on data only from farm animals in Scotland and not taking into account wider sources of resistance, such as imported food.
Lead author Professor Stuart Reid says they do admit that imported food in particular could be a 'significant source' of the antibiotic resistance found in humans - hence the use of the term 'local animal population' in their conclusions. He also had concerns that restricting antibiotic use in domestic farming would be of limited use if resistance spread from other countries, which have lax regulations.
Now Principal at the Royal Veterinary College, Professor Reid says neither he nor the other authors dispute that the use of antibiotics in farming promotes resistance, but that it was time to end what he sees as the 'excessive' focus on farm use.
'If we unilaterally take out antimicrobials or reduce them and don't ensure we're playing a part in a global reduction, we could export our industry to other parts of the world that aren't observing our standards,' he says. 'We're not arguing that there shouldn't be prudent use and reduction but we've got to look at all the sources.'
However, for campaigners, the study goes too far in questioning EU moves to restrict antimicrobial use in farm animals. Particularly at a time when researchers are finding more examples of antibiotic-resistant strains of the superbugs in food and animals, like MRSA in UK dairy cows and pig herds across Europe.
'It is irresponsible to make such sweeping claims based on one study,' says Richard Young, Soil Association animal health advisor, 'it adds fuel to the fire of those seeking to block any campaigns for more prudent use of farm antibiotics...and has already been used to bolster beliefs in the veterinary and farming sectors that antibiotic resistance in farm animals makes no significant contribution to resistance in humans.'
That similar data and results were also published in another journal by the same authors, but without the same bold conclusions, is only adding to campaigners anger at the study and the headlines it generated.
| READ MORE... | |
 |
NEWS ANALYSIS Common infections will be 'untreatable' if antibiotic misuse continues Scientists in new warning on post-antibiotic age as campaigners call for stronger controls on excessive use in intensive farming |
 |
NEWS ANALYSIS Overuse of drugs in animal farming linked to growing antibiotic-resistance in humans Urgent calls from health experts to reduce antibiotic use on intensive farms are largely resisted by the agribusiness food lobby, who downplay its role in the spread of antibiotic resistance in humans. Tom Levitt reports |
 |
NEWS ANALYSIS 'Routine antibiotic use' linked to new MRSA strain found in UK dairy cows Fresh concerns over the spread of antibiotic-resistant infections from farm animals to humans have been raised after scientists find new strain of potentially deadly superbug in dairy cows |
 |
NEWS UK rejects veterinary advice to ban antibiotic drug adverts to farmers Strong industry lobbying sees Defra ignore concerns from its own vets about overuse and the spread of antibiotic-resistant bugs from farm animals to the food chain |
 |
COMMENT Antibiotics under the spotlight The overuse of antibiotics in intensive farming could have devastating consequences for human health. What's more, the safety of some antibiotics used in human medicine has been challenged by some patients who say they've suffered terrifying side effects... |